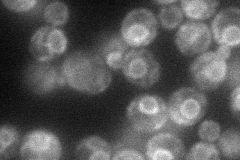
YKR067W
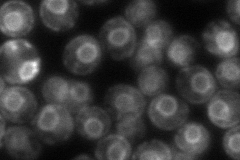
YKR067W
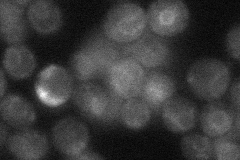
YKR067W
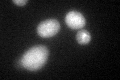
YKR067W
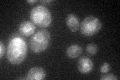
YKR067W

View description
Glycerol-3-phosphate/dihydroxyacetone phosphate dual substrate-specific sn-1 acyltransferase located in lipid particles and the ER; involved in the stepwise acylation of glycerol-3-phosphate and dihydroxyacetone in lipid biosynthesis
Localization:
Intensity:
Fold change:
Significance:
-
C’ GFP library in SD

ER31 -
N' NOP1pr-GFP in SD
ER47.318 -
N' TEF2pr-mCherry in SD
ER84.8813 -
N' NATIVEpr-GFP in SD
ER27.3271 -
N' TEF2pr-VC and Cyto-VN in SD

ER36.9611 -
C’ GFP library in SD+DTT
ER32.551.04No -
C’ GFP library in SD+H2O2

ER46.261.49Yes -
C’ GFP library in Starvation Media
ER54.91.77Yes -
C’ GFP library on the background of Pup2-DaMP

ER -
C’ GFP library on the background of CCT mutant

ER23.80490.767604No
